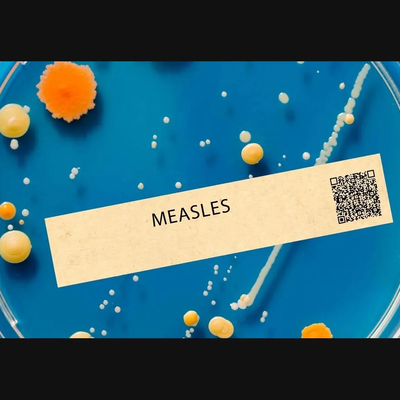

FDA approves at-home HPV tests, could boost cervical cancer screening in Davidson County

By Danielle
Published on April 24, 2026.
The U.S. Food and Drug Administration has approved at-home tests for human papillomavirus (HPV), a virus that can sometimes lead to cervical cancer. This could make it easier for more people to get screened, particularly those who have avoided in-office exams. A study by Vanderbilt University found that 77% of Davidson County women with invasive cervical cancer did not receive recommended screening or follow-up before diagnosis. The World Health Organization has stated that HPV vaccination and regular screenings can reduce cervical cancer cases by up to 90-99%.